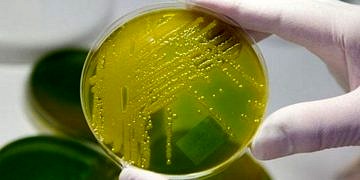
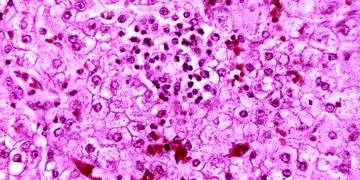
Amibik apse nedir? Belirtileri, tanı ve tedavisi

Azerbaycan Tıp Üniversiteleri ve Eğitim Avantajları
Azerbaycan, özellikle eğitim alanında yaptığı yatırımlar ve uluslararası öğrencilere sunduğu fırsatlarla dikkatleri üzerine çekiyor. Azerbaycan tıp üniversiteleri, sağlık eğitiminde yenilikçi yaklaşımları...